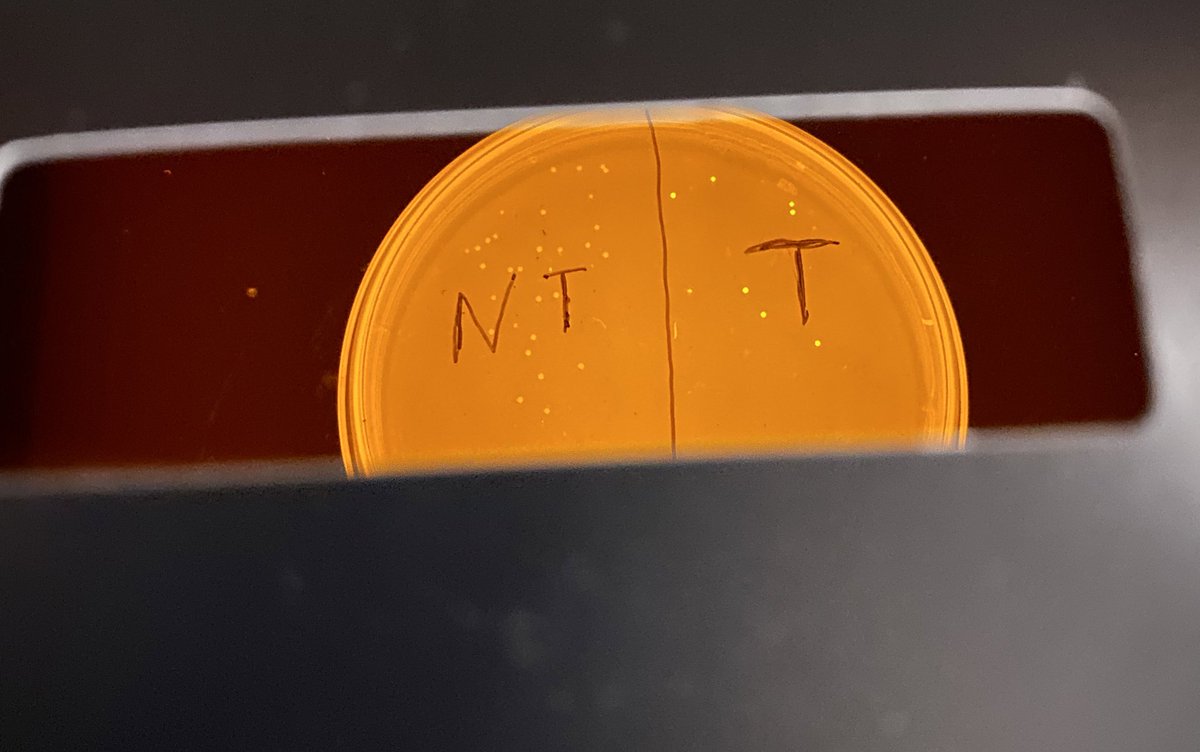
KomorLab's tweet image. We had a blast this week at @uchighsd  where we took over Mrs. Bosch’s Medical Interventions class to teach her students about #CRISPR and #baseediting! The students were given bacteria suffering from “GFP-itis” and successfully cured them with an ABE!

#baseediting search results
CRISPR free base editing. A pair of TALEs fused with a FokI nickase, a single-strand-specific cytidine deaminase and an exonuclease caused efficient base editing in nuclear, mitochondrial and chloroplast genomes. nature.com/articles/s4158… #BaseEditing #GenomeEditing #CRISPR

My first conference at the 4th International Conference on Base Editing (Deaminet 2023). Honoured to be sharing my work through a talk and meeting base editing pioneers and developers at Palm Springs! #stevejacksonlab #cruk_ci #baseediting #dnadamagerepair

With new technologies like #BaseEditing, VCs will often take a portfolio approach. They can ride the winners, which in theory, will make up for the losers. Do you think this approach will work for public market investors? #learnbiotechinvesting #BiotechPrometheus


Do you want to know why hashtag#ABE8e is the most efficient adenine base editor? Read our paper with the amazing @Sarkele1 @NAR_Open! The dimerization of TadA8e and its exclusive interactions with #CRISPR Cas9 boost #BaseEditing efficiency! academic.oup.com/nar/advance-ar…

Investors should stay on top of new technologies in biotech. Though #geneediting is new, there are multiple methods in public companies to edit the genome at the DNA level: #CrisprCas9, #BaseEditing #PrimeEditing Here is a quick description of each

Base editing - google search interest over time. #BaseEditing #PrimeEditing #CRISPR #BioTech #Science #Technology
#SpinalMuscularAtrophy occurs when cells in the spinal cord that control muscle movement, called motor neurons, die. Dr. @DavidRLiu's team at the @BroadInstitute used #BaseEditing to restore motor function in an animal model of the disease. 🧬 🔗 bit.ly/3m2qc0W

Adenine #BaseEditing corrected a #MYH7 pathogenic variant that causes hypertrophic #cardiomyopathy in human cardiomyocytes & a mouse model, highlighting the potential of the approach to correct monogenic variants causing #CardiacCisease. @utsw go.nature.com/3YAQuWn

CRISPR technologies for genome, epigenome and transcriptome editing Dazzling, ever-expanding Cas-verse😎 #BaseEditing #PrimeEditing Large insertions/deletion kb Transient/Stable transcriptional activation/inhibition RNA degradation/editing/methylation🤠 @lukas_villiger…

#BaseEditing Is Superior in Lab Test of Sickle Cell Disease Gene Therapy Adenine base editors were the most promising type of #genetherapy in #sicklecelldisease and #betathalassemia in research from @StJudeResearch and the @broadinstitute. Learn more: ow.ly/l9fy50P466Z

.@novonordisk entered a research and development deal with @LifeEditTx to leverage its next-generation #geneediting technologies. Learn more: ow.ly/ae5850OvLXR #BaseEditing

Learn how to achieve efficient CAR-T cell generation in a single intervention with multiplex gene editing using the Pin-point™ base editing platform. ms.spr.ly/6019o8sy9 #BaseEditing #GeneEditing
Single Nucleotide Edit Fixes Heart Muscle Disease Precisely editing just a single nucleotide in the genome could help clinically correct #cardiomyopathies, a proof-of-concept study suggests @XurdeMC #baseediting #iPSCs #genes hubs.li/Q03NHJX_0
#AI Tool Expands #BaseEditing Capabilities by Uncovering New Enzymes Researchers develop new base editing tools using AI-predicted protein structure clustering. Learn more: ow.ly/NbuT50OZkFz

Researchers in Sebastian Soyk's laboratory at the Swiss University of Lausanne used #baseediting to make tomatoes yield earlier. Read details in #BiotechUpdates: bit.ly/3Eg4PSs

At Chardan Conference, David Liu Foresees First Prime Editing Clinical Trial in 2024 Genome editing pioneer David R. Liu, PhD, tells investors #primeediting is on track to join #baseediting in human clinical trials in less than a year. Learn more: ow.ly/OWFH50PVjQY

.@AstraZeneca Licenses @RevvityInc’s Pin-Point #BaseEditing Technology Revvity has secured a non-exclusive license with AstraZeneca for the use of its single-strand base editing technology. Learn more: ow.ly/rgcM50Ork6P

Here’s the important data from $VERV-201 Thanks to @drpablocorral for the images. $BEAM #BaseEditing #CRISPR

“I had hemophilia for nearly five decades. I went to Philadelphia and had a 45-minute infusion, and my hemophilia was gone.” Genes-> Medicine @NatureMedicine nature.com/articles/s4159…

They’re always halfway into everything and done with nothing! We are yet to bring original #CRISPR #baseEditing #primeEditing #curative surgeries to life, combating what can be treated NOW!
Started yesterday🛫#CRISPR #baseEditing #primeEditing pioneers unwinding resumed - #FDA plausible regulatory 🖼️ can be all they need to realize the original promises of #geneTherapy #geneSurgery $CRSP $BEAM $NTLA $EDIT $PRME $CRBU $arkG with $QURE $RGNX $SRPT $LEGN $allo proxies
📢2bad MM managed to bring it👎to $50s - #CRISPR #baseEditing #primeEditing pioneers are not for sale at these level, this is not your $MRSN via $PFE, or $CDTX via $MRK - this is a new era of #trasnformative #curable #gene surgeries $NTLA $PRME $arkg seekingalpha.com/news/4523001-c…
📢VERY SIMPLE - if you can, BUY this #geneTherapy #CRISPR #baseEditing #primeEditing unreasonable crush $BEAM $CRSP $EDIT $VRTX $NTLA $PRME $CRBU $RGNX $QURE $LEGN $IBB $XBI $XLV
📢this is worth MORE than ALL major #geneTherapy #CRISPR #baseEditing #primeEditing market - TOTALLY INSANE⁉️if you can pls hold off selling now $BEAM $CRSP $EDIT $VRTX $NTLA $PRME $CRBU $RGNX $QURE $LEGN⬅️ $LLY $MRK $AZN $NVS $NVO $AMGN $REGN $MRK via zacks.com/stock/news/279…
📢this is worth MORE than ALL major #geneTherapy #CRISPR #baseEditing #primeEditing market - TOTALLY INSANE⁉️if you can pls hold off selling now $BEAM $CRSP $EDIT $VRTX $NTLA $PRME $CRBU $RGNX $QURE $LEGN⬅️ $LLY $MRK $AZN $NVS $NVO $AMGN $REGN $MRK via zacks.com/stock/news/279…
$155 for $CDTX was the “stab in the dark” guess of a man who was deeply scarred by the last 3 years of vicious biotech bear market 😅 That said, the actual bid of $221.50 is an INCREDIBLE premium for $CDTX. Biotech M&A is on the hottest streak I’ve ever seen not only in terms…
CRISPR free base editing. A pair of TALEs fused with a FokI nickase, a single-strand-specific cytidine deaminase and an exonuclease caused efficient base editing in nuclear, mitochondrial and chloroplast genomes. nature.com/articles/s4158… #BaseEditing #GenomeEditing #CRISPR

#BaseEditing Is Superior in Lab Test of Sickle Cell Disease Gene Therapy Adenine base editors were the most promising type of #genetherapy in #sicklecelldisease and #betathalassemia in research from @StJudeResearch and the @broadinstitute. Learn more: ow.ly/l9fy50P466Z

We had a blast this week at @uchighsd where we took over Mrs. Bosch’s Medical Interventions class to teach her students about #CRISPR and #baseediting! The students were given bacteria suffering from “GFP-itis” and successfully cured them with an ABE!

Investors should stay on top of new technologies in biotech. Though #geneediting is new, there are multiple methods in public companies to edit the genome at the DNA level: #CrisprCas9, #BaseEditing #PrimeEditing Here is a quick description of each

With new technologies like #BaseEditing, VCs will often take a portfolio approach. They can ride the winners, which in theory, will make up for the losers. Do you think this approach will work for public market investors? #learnbiotechinvesting #BiotechPrometheus


.@novonordisk entered a research and development deal with @LifeEditTx to leverage its next-generation #geneediting technologies. Learn more: ow.ly/ae5850OvLXR #BaseEditing

#AI Tool Expands #BaseEditing Capabilities by Uncovering New Enzymes Researchers develop new base editing tools using AI-predicted protein structure clustering. Learn more: ow.ly/NbuT50OZkFz

#SpinalMuscularAtrophy occurs when cells in the spinal cord that control muscle movement, called motor neurons, die. Dr. @DavidRLiu's team at the @BroadInstitute used #BaseEditing to restore motor function in an animal model of the disease. 🧬 🔗 bit.ly/3m2qc0W

One-Time Treatment: Base Editing Shows Promise vs. SMA A team led by @davidrliu has published how it has applied #baseediting to develop a one-time treatment for #spinalmuscularatrophy that showed effectiveness in cell and mouse models. Read more: ow.ly/37o950NwnsN

VP of Gene Editing Stefano Stella presented on the Optimization of #BaseEditing based on Cas12a variants at #EMBOCRISPRCas this week, and enjoyed many other fascinating sessions with colleagues. Thank you, @EMBOevents, for this inspiring week!


At Chardan Conference, David Liu Foresees First Prime Editing Clinical Trial in 2024 Genome editing pioneer David R. Liu, PhD, tells investors #primeediting is on track to join #baseediting in human clinical trials in less than a year. Learn more: ow.ly/OWFH50PVjQY

Base Editing Beats Other Genome Editing Strategies for Treating Sickle Cell Disease Scientists found #baseediting increased fetal hemoglobin production in a new #sicklecelldisease and #betathalassemia treatment. Learn more: ow.ly/SEHJ50P692q

Adenine #BaseEditing corrected a #MYH7 pathogenic variant that causes hypertrophic #cardiomyopathy in human cardiomyocytes & a mouse model, highlighting the potential of the approach to correct monogenic variants causing #CardiacCisease. @utsw go.nature.com/3YAQuWn

How can #BaseEditing improve #CART for blood cancers? Drs. @CarlHJune, Saar Gill, & a team at @PennMedicine developed epitope-edited CD45 CAR T cells that were effective against several hematologic malignancies. 🩸 @ScienceTM: bit.ly/3sIFDOT ▶️: bit.ly/3ZxuwVz

Do you want to know why hashtag#ABE8e is the most efficient adenine base editor? Read our paper with the amazing @Sarkele1 @NAR_Open! The dimerization of TadA8e and its exclusive interactions with #CRISPR Cas9 boost #BaseEditing efficiency! academic.oup.com/nar/advance-ar…

.@AstraZeneca Licenses @RevvityInc’s Pin-Point #BaseEditing Technology Revvity has secured a non-exclusive license with AstraZeneca for the use of its single-strand base editing technology. Learn more: ow.ly/rgcM50Ork6P

CRISPR technologies for genome, epigenome and transcriptome editing Dazzling, ever-expanding Cas-verse😎 #BaseEditing #PrimeEditing Large insertions/deletion kb Transient/Stable transcriptional activation/inhibition RNA degradation/editing/methylation🤠 @lukas_villiger…

Here’s the important data from $VERV-201 Thanks to @drpablocorral for the images. $BEAM #BaseEditing #CRISPR

By several rounds of MPG mutagenesis via rational screening, we obtained gGBEv6.3 which could increase G editing efficiency by more than 1,500 folds. @CRISPR_News @CRISPRjournal @ASGCTherapy #BaseEditing #GeneTherapy

Something went wrong.
Something went wrong.
United States Trends
- 1. Araujo 105K posts
- 2. Estevao 86.7K posts
- 3. Ferran 53.8K posts
- 4. Chelsea 413K posts
- 5. Barcelona 307K posts
- 6. Rashford 20.6K posts
- 7. Yamal 80.9K posts
- 8. Cucurella 36.3K posts
- 9. Godzilla 22.7K posts
- 10. #CHEBAR 10K posts
- 11. Rush Hour 4 16K posts
- 12. Kounde 25.6K posts
- 13. #AskTems 3,957 posts
- 14. Sonny Gray 8,542 posts
- 15. Happy Thanksgiving 23.1K posts
- 16. Flick 26.3K posts
- 17. Enzo 42.9K posts
- 18. Raising Arizona 1,322 posts
- 19. Balde 8,599 posts
- 20. Caicedo 20.7K posts

























